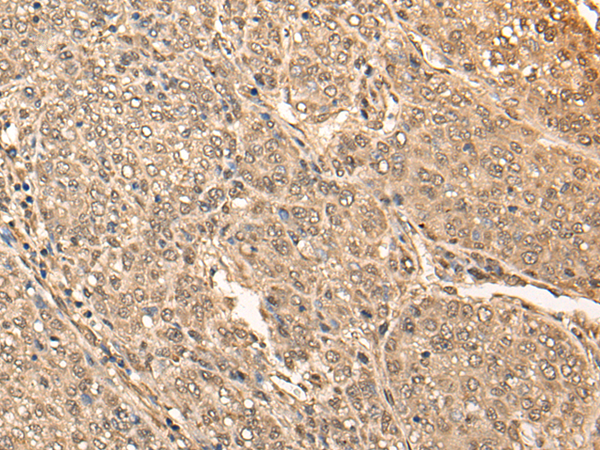
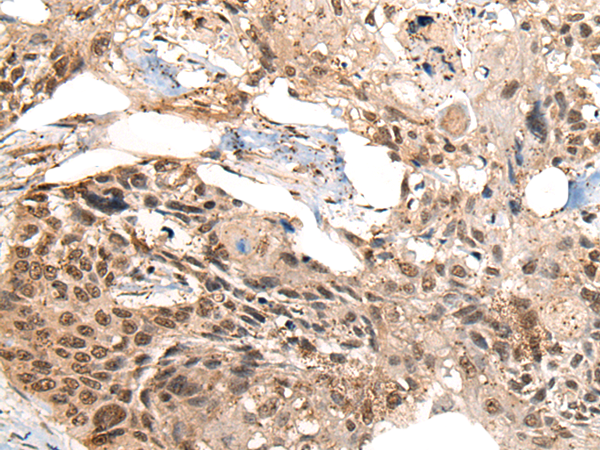
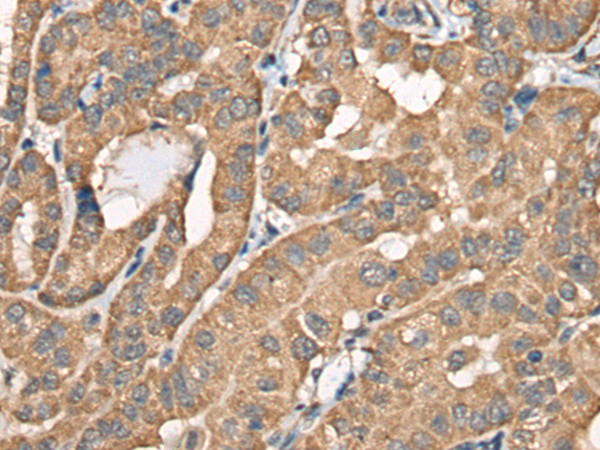

-
分类: 科研抗体货号: P09371别名: BRFU; TFIIIB50应用: IHC反应种属: Human
-
分类: 科研抗体货号: P09370别名: BEHAB; CSPG7应用: IHC反应种属: Human, Mouse, Rat
-
分类: 科研抗体货号: P09384别名: HEL-206; HEL-S-94应用: IHC反应种属: Human
-
分类: 科研抗体货号: P09369别名: BRDG1; STAP-1应用: IHC反应种属: Human, Mouse
-
分类: 科研抗体货号: P09399别名: C1orf101; C10orf101应用: IHC反应种属: Human
-
分类: 科研抗体货号: P09383别名: MYG; MYG1; Gamm1; MST024; MSTP024应用: WB,IHC反应种属: Human
-
分类: 科研抗体货号: P09368别名: PRO9856; SMARCI2; LAVS3040应用: WB,IHC反应种属: Human, Mouse
-
分类: 科研抗体货号: P09398别名: RIF1; C1orf103应用: IHC反应种属: Human
-
分类: 科研抗体货号: P09382别名: E1; CHE1; CHE2应用: IHC反应种属: Human, Mouse
-
分类: 科研抗体货号: P09367别名: BP75; NAG4; CELTIX1应用: IHC反应种属: Human, Mouse

鄂公网安备42018502007531号
鄂公网安备42018502007531号

